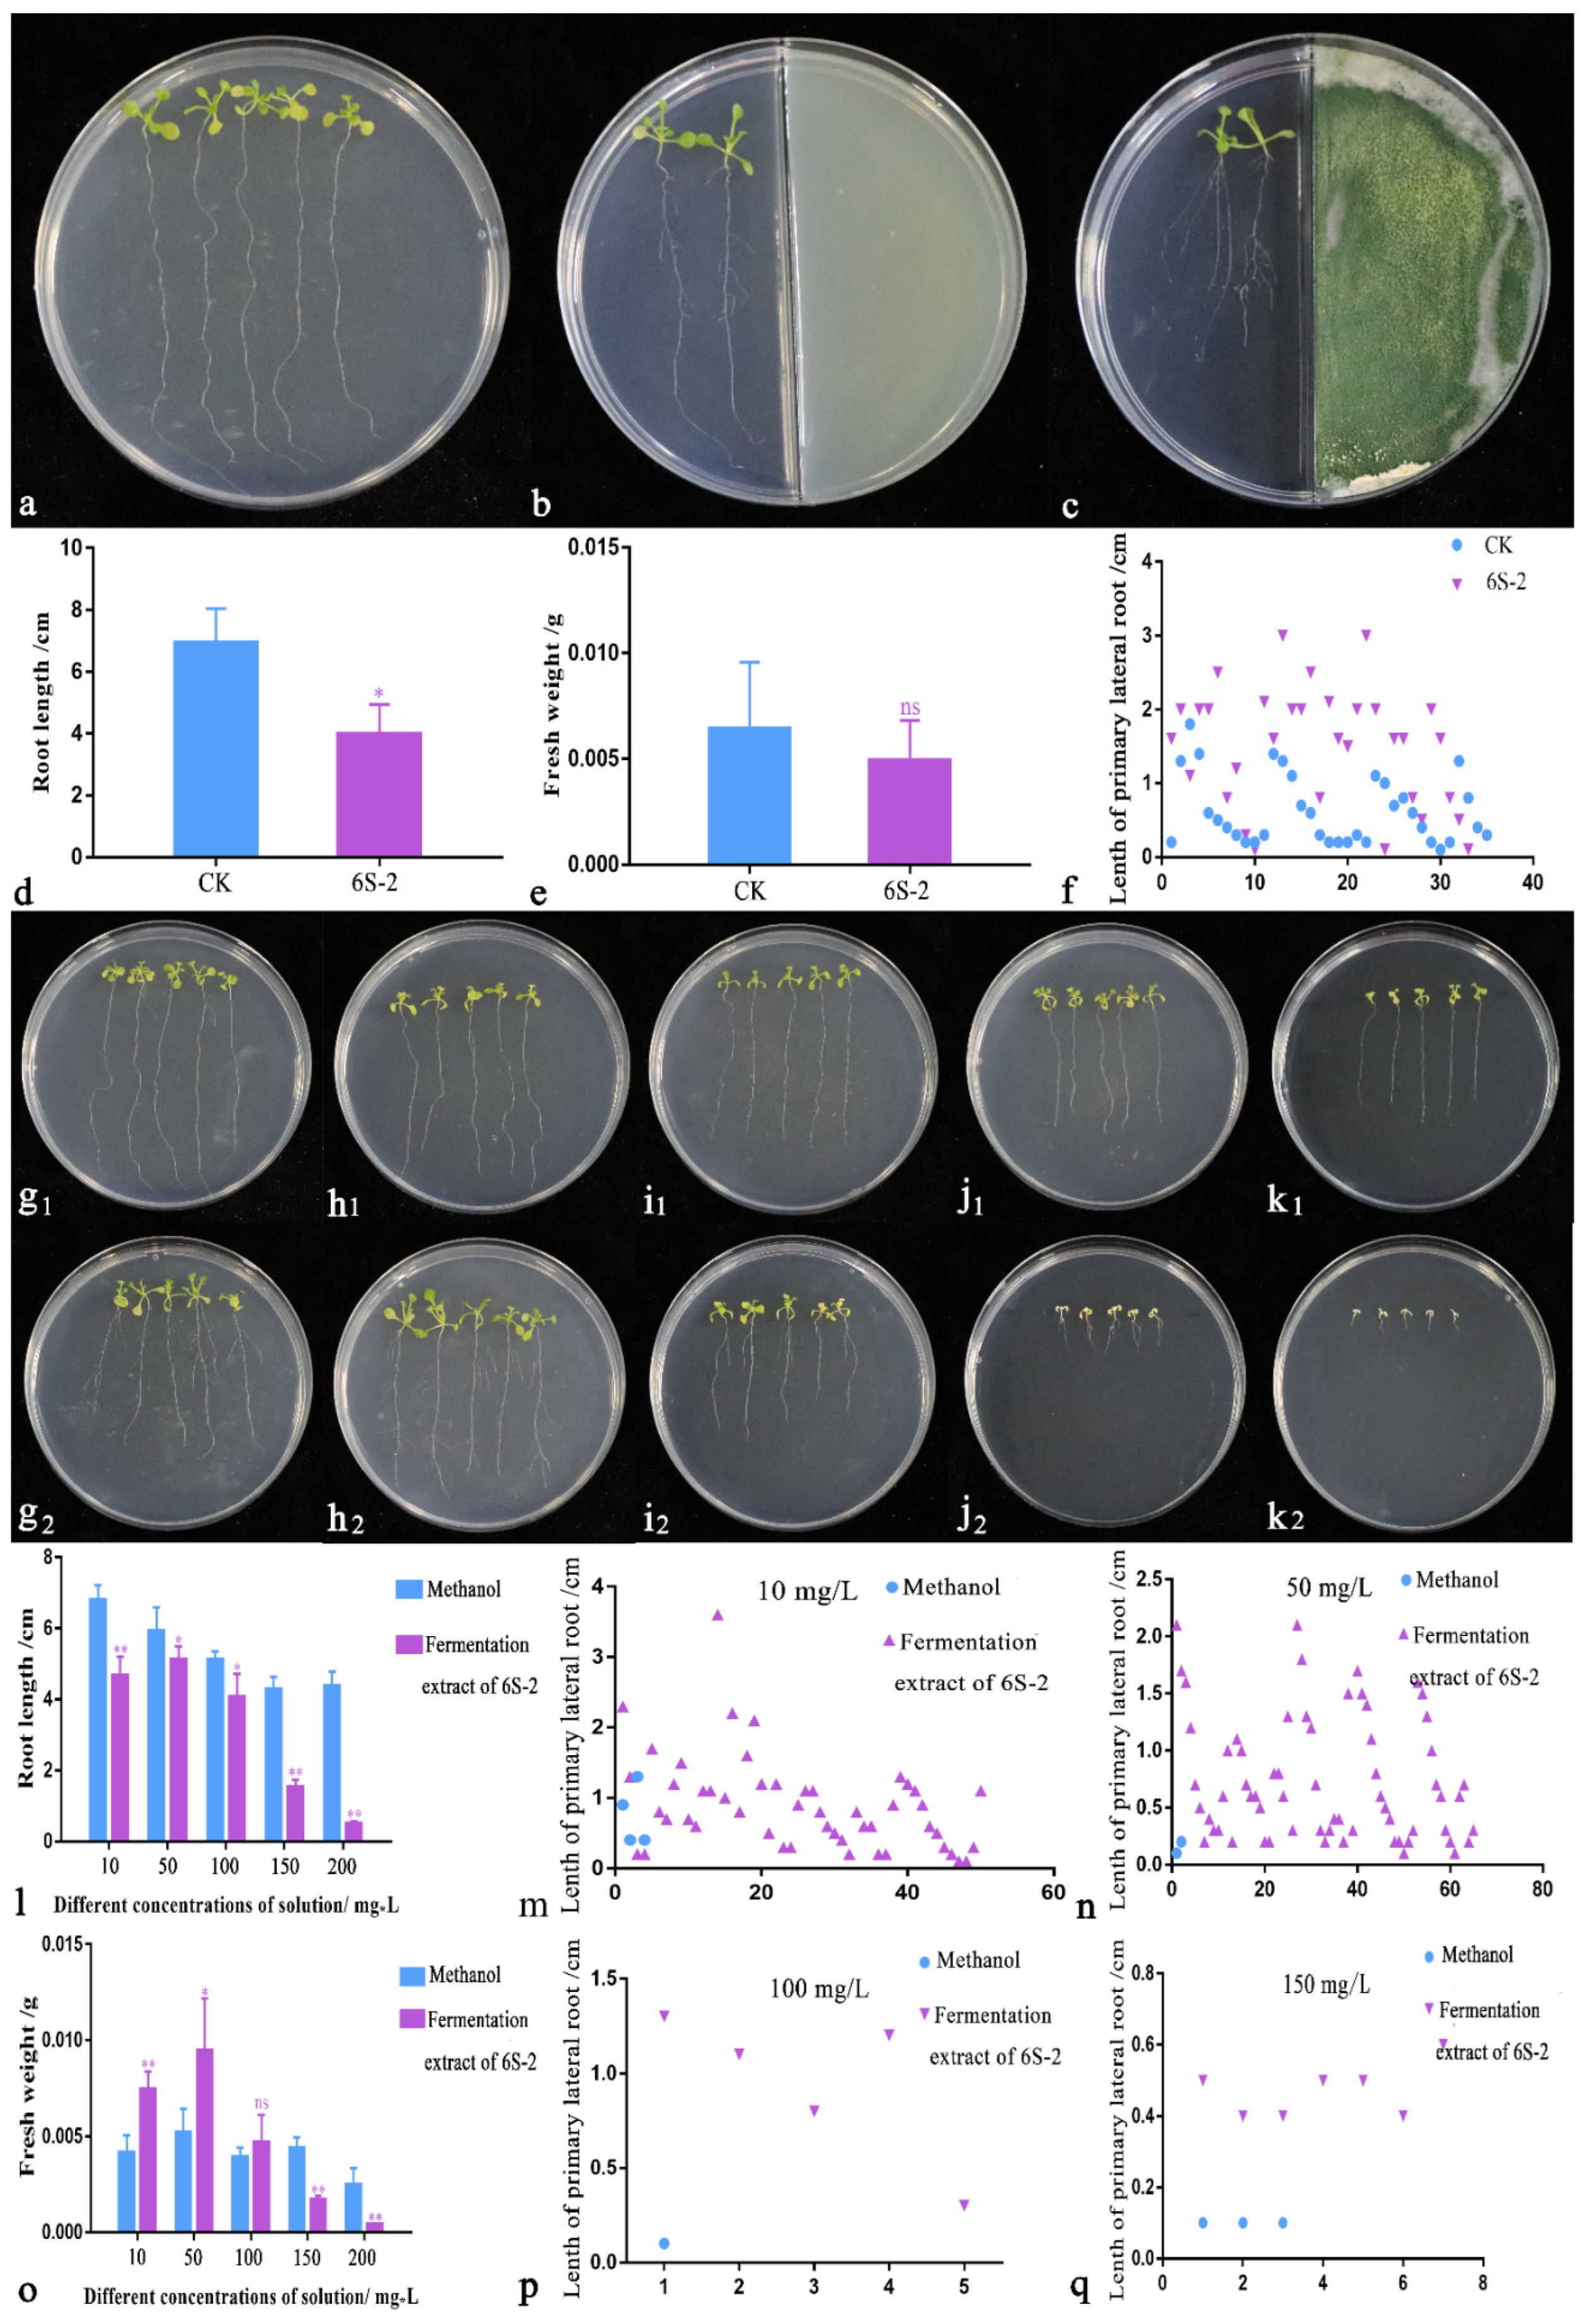
Jof 07 01050 g006

The Endophytic Strain Trichoderma asperellum 6S-2: An Efficient Biocontrol Agent against Apple Replant Disease in China and a Potential Plant-Growth-Promoting Fungus
Abstract
:1. Introduction
2. Materials and Methods
2.1. Experimental Design
2.1.1. Field Soil Samples for Screening of Endophytic Fungal Strains
2.1.2. Field Soil Samples for Pot Experiments
2.2. Measurement Index
2.2.1. Soil-Related Indicators
Soil DNA Extraction and Terminal-Restriction Fragment Length Polymorphism (T-RFLP) Analysis
Soil Culturable Microorganisms and Real-Time Fluorescence Quantification of Four Fusarium Species
2.2.2. Isolation of Endophytic Fungi Antagonistic to MR5 and Verification by Re-Screening
Isolation of Endophytic Fungi from Healthy Apple Roots
Dual Culture Test with MR5
Re-Isolation of Endophytes
2.2.3. Strain Identification
Morphological Identification
Molecular Biology Identification
2.2.4. Media
2.2.5. Preparation of 6S-2 Liquid Fermentation Extract
2.2.6. Production of 6S-2 Spore Powder
2.2.7. Antifungal Tests
Plate Confrontation Test with Multiple Pathogenic Fungi
Cellophane Culture Antifungal Test
Oxford Cup Test
Antifungal Experiment with Different Concentrations of Liquid Fermentation Extract
Antifungal Experiment with 6S-2 Volatile Substances
Spore Germination Test
2.2.8. Microscopy and Electron Microscopy Observations
2.2.9. Analysis of Liquid Fermentation Extract and Volatile Substance
2.2.10. Plant Related Indicators
Arabidopsis thaliana Disinfection
Growth Promotion Experiment with Liquid Fermentation Extract
Growth Promotion Experiment with Volatile Substances
Nitro Blue Tetrazolium (NBT) Staining
DAB (3,3′-Diaminobenzidine) Staining
M. hupehensis Seedling Growth and Biomass
Photosynthetic Characteristics of M. hupehensis Seedlings
Root Protective Enzyme Activities and Malondialdehyde (MDA) Content of M. hupehensis Seedlings
3. Results
3.1. T-RFLP Analysis of Soil Fungi
3.2. Isolation of Endophytic Fungi Antagonistic to MR5 and Verification by Re-Screening
3.3. Identification and Functional Analysis of 6S-2
3.3.1. Morphological Identification and Functions
3.3.2. Molecular Biology Identification
3.4. Analysis of 6S-2 Antagonistic Activity
3.4.1. Analysis of Antagonistic Activity by Plate Confrontation
3.4.2. Antifungal Activity of Liquid Fermentation Extract
3.4.3. Antifungal Analysis of Volatile Substances
3.5. Arabidopsis thaliana Growth Promotion Test
3.6. GC-MS Analysis
3.7. Effects of 6S-2 Fertilizer Containing Spore Powder in Pot Experiments
4. Discussion
5. Conclusions
Supplementary Materials
Author Contributions
Funding
Acknowledgments
Conflicts of Interest
References
- Mazzola, M.; Manici, L.M. Apple Replant Disease: Role of Microbial Ecology in Cause and Control. Annu. Rev. Phytopathol. 2012, 50, 45–65. [Google Scholar] [CrossRef]
- Spath, M.; Insam, H.; Peintner, U.; Kelderer, M.; Kuhnert, R.; Franke-Whittle, I.H. Linking Soil Biotic and Abiotic Factors to Apple Replant Disease: A Greenhouse Approach. J. Phytopathol. 2014, 163, 287–299. [Google Scholar] [CrossRef]
- Manici, L.M.; Kelderer, M.; Caputo, F.; Saccà, M.L.; Nicoletti, F.; Topp, A.R.; Mazzola, M. Involvement of Dactylonectria and Ilyonectria spp. in tree decline affecting multi-generation apple orchards. Plant Soil 2018, 425, 217–230. [Google Scholar] [CrossRef]
- van Schoor, L.; Denman, S.; Cook, N. Characterisation of apple replant disease under South African conditions and potential biological management strategies. Sci. Hortic. 2009, 119, 153–162. [Google Scholar] [CrossRef]
- Tewoldemedhin, Y.T.; Mazzola, M.; Botha, W.J.; Spies, C.F.J.; McLeod, A. Characterization of fungi (Fusarium and Rhizoctonia) and oomycetes (Phytophthora and Pythium) associated with apple orchards in South Africa. Eur. J. Plant Pathol. 2011, 130, 215–229. [Google Scholar] [CrossRef]
- Caputo, F.; Nicoletti, F.; Picione, F.D.L.; Manici, L. Rhizospheric changes of fungal and bacterial communities in relation to soil health of multi-generation apple orchards. Biol. Control 2015, 88, 8–17. [Google Scholar] [CrossRef]
- Wang, G.; Yin, C.; Pan, F.; Wang, X.; Xiang, L.; Wang, Y.; Wang, J.; Tian, C.; Chen, J.; Mao, Z. Analysis of the Fungal Community in Apple Replanted Soil around Bohai Gulf. Hortic. Plant J. 2018, 4, 175–181. [Google Scholar] [CrossRef]
- Lu, Z.-X.; Tu, G.-P.; Zhang, T.; Li, Y.-Q.; Wang, X.-H.; Zhang, Q.-G.; Song, W.; Chen, J. Screening of antagonistic Trichoderma strains and their application for controlling stalk rot in maize. J. Integr. Agric. 2020, 19, 145–152. [Google Scholar] [CrossRef]
- Harman, G.E.; Howell, C.R.; Viterbo, A.; Chet, I.; Lorito, M. Trichoderma species—Opportunistic, avirulent plant symbionts. Nat. Rev. Genet. 2004, 2, 43–56. [Google Scholar] [CrossRef]
- Hu, D.; Li, S.; Li, Y.; Peng, J.; Wei, X.; Ma, J.; Zhang, C.; Jia, N.; Wang, E.; Wang, Z. Streptomyces sp. strain TOR3209: A rhizosphere bacterium promoting growth of tomato by affecting the rhizosphere microbial community. Sci. Rep. 2020, 10, 20132. [Google Scholar] [CrossRef]
- Maciag, T.; Krzyzanowska, D.M.; Jafra, S.; Siwinska, J.; Czajkowski, R. The Great Five—An artificial bacterial consortium with antagonistic activity towards Pectobacterium spp. and Dickeya spp.: Formulation, shelf life, and the ability to prevent soft rot of potato in storage. Appl. Microbiol. Biotechnol. 2020, 104, 4547–4561. [Google Scholar] [CrossRef] [PubMed] [Green Version]
- Bogner, C.W.; Kariuki, G.M.; Elashry, A.; Sichtermann, G.; Buch, A.-K.; Mishra, B.; Thines, M.; Grundler, F.M.; Schouten, A. Fungal root endophytes of tomato from Kenya and their nematode biocontrol potential. Mycol. Prog. 2016, 15, 30. [Google Scholar] [CrossRef]
- Saad, M.M.G.; Ghareeb, R.Y.; Saeed, A.A. The potential of endophytic fungi as bio-control agents against the cotton leafworm, Spodoptera littoralis (Boisd.) (Lepidoptera: Noctuidae). Egypt. J. Biol. Pest Control 2019, 29, 7. [Google Scholar] [CrossRef]
- Poveda, J.; Eugui, D.; Abril-Urías, P.; Velasco, P. Endophytic fungi as direct plant growth promoters for sustainable agricultural production. Symbiosis 2021, 85, 1–19. [Google Scholar] [CrossRef]
- Poveda, J. Beneficial effects of microbial volatile organic compounds (MVOCs) in plants. Appl. Soil Ecol. 2021, 168, 104118. [Google Scholar] [CrossRef]
- De Almeida, A.B.; Concas, J.; Campos, M.D.; Materatski, P.; Varanda, C.; Patanita, M.; Murolo, S.; Romanazzi, G.; Félix, M.D.R. Endophytic Fungi as Potential Biological Control Agents against Grapevine Trunk Diseases in Alentejo Region. Biology 2020, 9, 420. [Google Scholar] [CrossRef]
- Veselova, M.A.; Plyuta, V.A.; Khmel, I.A. Volatile Compounds of Bacterial Origin: Structure, Biosynthesis, and Biological Activity. Microbiology 2019, 88, 261–274. [Google Scholar] [CrossRef]
- Poveda, J.; Hermosa, R.; Monte, E.; Nicolás, C. Trichoderma harzianum favours the access of arbuscular mycorrhizal fungi to non-host Brassicaceae roots and increases plant productivity. Sci. Rep. 2019, 9, 11650. [Google Scholar] [CrossRef] [PubMed] [Green Version]
- Poveda, J. Trichoderma parareesei Favors the Tolerance of Rapeseed (Brassica napus L.) to Salinity and Drought Due to a Chorismate Mutase. Agronomy 2020, 10, 118. [Google Scholar] [CrossRef] [Green Version]
- Poveda, J.; Abril-Urias, P.; Escobar, C. Biological Control of Plant-Parasitic Nematodes by Filamentous Fungi Inducers of Resistance: Trichoderma, Mycorrhizal and Endophytic Fungi. Front. Microbiol. 2020, 11, 992. [Google Scholar] [CrossRef]
- Poveda, J. Trichoderma as biocontrol agent against pests: New uses for a mycoparasite. Biol. Control 2021, 159, 104634. [Google Scholar] [CrossRef]
- Poveda, J. Biological control of Fusarium oxysporum f. sp. ciceri and Ascochyta rabiei infecting protected geographical indication Fuentesaúco-Chickpea by Trichoderma species. Eur. J. Plant Pathol. 2021, 160, 825–840. [Google Scholar] [CrossRef]
- Sunpapao, A.; Chairin, T.; Ito, S.-I. The biocontrol by Streptomyces and Trichoderma of leaf spot disease caused by Curvularia oryzae in oil palm seedlings. Biol. Control 2018, 123, 36–42. [Google Scholar] [CrossRef]
- Halifu, S.; Deng, X.; Song, X.; Song, R. Effects of Two Trichoderma Strains on Plant Growth, Rhizosphere Soil Nutrients, and Fungal Community of Pinus sylvestris var. mongolica Annual Seedlings. Forests 2019, 10, 758. [Google Scholar] [CrossRef] [Green Version]
- Baiyee, B.; Pornsuriya, C.; Ito, S.-I.; Sunpapao, A. Trichoderma spirale T76-1 displays biocontrol activity against leaf spot on lettuce (Lactuca sativa L.) caused by Corynespora cassiicola or Curvularia aeria. Biol. Control 2019, 129, 195–200. [Google Scholar] [CrossRef]
- Aamir, M.; Kashyap, S.P.; Zehra, A.; Dubey, M.K.; Singh, V.K.; Ansari, W.A.; Upadhyay, R.S.; Singh, S. Trichoderma erinaceum Bio-Priming Modulates the WRKYs Defense Programming in Tomato Against the Fusarium oxysporum f. sp. lycopersici (Fol) Challenged Condition. Front. Plant Sci. 2019, 10, 911. [Google Scholar] [CrossRef] [Green Version]
- Wonglom, P.; Ito, S.-I.; Sunpapao, A. Volatile organic compounds emitted from endophytic fungus Trichoderma asperellum T1 mediate antifungal activity, defense response and promote plant growth in lettuce (Lactuca sativa). Fungal Ecol. 2020, 43, 100867. [Google Scholar] [CrossRef]
- Oszako, T.; Voitka, D.; Stocki, M.; Stocka, N.; Nowakowska, J.A.; Linkiewicz, A.; Hsiang, T.; Belbahri, L.; Berezovska, D.; Malewski, T. Trichoderma asperellum efficiently protects Quercus robur leaves against Erysiphe alphitoides. Eur. J. Plant Pathol. 2021, 159, 295–308. [Google Scholar] [CrossRef]
- Harman, G.E.; Doni, F.; Khadka, R.B.; Uphoff, N. Endophytic strains of Trichoderma increase plants’ photosynthetic capability. J. Appl. Microbiol. 2021, 130, 529–546. [Google Scholar] [CrossRef]
- Minerdi, D.; Bossi, S.; Gullino, M.L.; Garibaldi, A. Volatile organic compounds: A potential direct long-distance mechanism for antagonistic action of Fusarium oxysporum strain MSA 35. Environ. Microbiol. 2009, 11, 844–854. [Google Scholar] [CrossRef]
- Stoppacher, N.; Kluger, B.; Zeilinger, S.; Krska, R.; Schuhmacher, R. Identification and profiling of volatile metabolites of the biocontrol fungus Trichoderma atroviride by HS-SPME-GC-MS. J. Microbiol. Methods 2010, 81, 187–193. [Google Scholar] [CrossRef]
- Pascale, A.; Vinale, F.; Manganiello, G.; Nigro, M.; Lanzuise, S.; Ruocco, M.; Marra, R.; Lombardi, N.; Woo, S.; Lorito, M. Trichoderma and its secondary metabolites improve yield and quality of grapes. Crop. Prot. 2017, 92, 176–181. [Google Scholar] [CrossRef] [Green Version]
- De Rezende, L.C.; de Andrade Carvalho, A.L.; Costa, L.B.; Vieira, B.D.A.H.; Silva, L.G.; Pinto, Z.V.; Morandi, M.A.B.; De Medeiros, F.H.V.; Mascarin, G.M.; Bettiol, W. Optimizing mass production of Trichoderma asperelloides by submerged liquid fermentation and its antagonism against Sclerotinia sclerotiorum. World J. Microbiol. Biotechnol. 2020, 36, 113. [Google Scholar] [CrossRef] [PubMed]
- Ruangwong, O.-U.; Wonglom, P.; Suwannarach, N.; Kumla, J.; Thaochan, N.; Chomnunti, P.; Pitija, K.; Sunpapao, A. Volatile Organic Compound from Trichoderma asperelloides TSU1: Impact on Plant Pathogenic Fungi. J. Fungi 2021, 7, 187. [Google Scholar] [CrossRef]
- Yin, C.M.; Wang, G.S.; Li, Y.Y.; Chen, X.S.; Wu, S.J.; Mao, Z.Q. Assessment of fungal diversity in apple replanted orchard soils by T-RFLP analysis. Acta Ecol. Sin. 2014, 34, 837–846. (In Chinese) [Google Scholar] [CrossRef]
- Somera, T.S.; Freilich, S.; Mazzola, M. Comprehensive analysis of the apple rhizobiome as influenced by different Brassica seed meals and rootstocks in the same soil/plant system. Appl. Soil Ecol. 2020, 157, 103766. [Google Scholar] [CrossRef]
- Shen, P.; Chen, X. Microbiology Experiment, 4th ed.; Education Press: Beijing, China, 2007. (In Chinese) [Google Scholar]
- Su, L.; Shen, Z.; Ruan, Y.; Tao, C.; Chao, Y.; Li, R.; Shen, Q. Isolation of Antagonistic Endophytes from Banana Roots against Meloidogyne javanica and Their Effects on Soil Nematode Community. Front. Microbiol. 2017, 8, 2070. [Google Scholar] [CrossRef]
- Manias, D.; Verma, A.; Soni, D.K. Isolation and characterization of endophytes: Biochemical and molecular approach. Microb. Endophytes 2020, 1–14. [Google Scholar] [CrossRef]
- Hewedy, O.A.; Lateif, K.S.A.; Seleiman, M.F.; Shami, A.; Albarakaty, F.M.; El-Meihy, R.M. Phylogenetic Diversity of Trichoderma Strains and Their Antagonistic Potential against Soil-Borne Pathogens under Stress Conditions. Biology 2020, 9, 189. [Google Scholar] [CrossRef]
- Wu, H.Q.; Su, J.Q.; Xie, M.Y.; Yang, M.H. An endophytic Trichoderma species from Camellia sinensis: Its characterization and endophytism. Mycosystema 2009, 28, 342–348. (In Chinese) [Google Scholar]
- Dar, R.A.; Rather, S.; Mushtaq, S.; Qazi, P. Purification and characterization of endophytic fungal strains from four different high value medicinal plants of Kashmir valley. Int. J. Phytopharm. Res. 2015, 5, 8–11. [Google Scholar] [CrossRef]
- White, T.J.; Bruns, T.; Lee, S.; Taylor, J.W. Amplification and direct sequencing of fungal ribosomal RNA genes for phylogenetics. In PCR Protocols: A Guide to Methods and Applications; Innis, M.A., Gelfand, D.H., Sninsky, J.J., White, T.J., Eds.; Academic Press: San Diego, CA, USA, 1990; pp. 315–322. [Google Scholar]
- Kullnig-Gradinger, C.M.; Szakacs, G.; Kubicek, C.P. Phylogeny and evolution of the genus Trichoderma: A multigene approach. Mycol. Res. 2002, 106, 757–767. [Google Scholar] [CrossRef]
- Yang, L.B.; Song, R.Q.; Li, C.W. Effects of ethyl acetate extract of Trichoderma harzianum fermentation liquid on physiological index of Phytophthora infestans. J. Beijing For. Univ. 2013, 35, 92–96. (In Chinese) [Google Scholar] [CrossRef]
- Zhang, C.; Liao, W.M.; Xue, M.; Chen, D.; Hou, J.M.; Liu, T. Conidia of Trichoderma asperellum DQ-1 fermented by solid state and its growth effect on four crop seedlings. Chin. J. Biol. Control. 2021, 37, 315–322. Available online: https://kns.cnki.net/kcms/detail/11.3515.S.20201027.0931.002.html (accessed on 25 August 2021). (In Chinese).
- Riccardi, C.; Nicoletti, I. Analysis of apoptosis by propidium iodide staining and flow cytometry. Nat. Protoc. 2006, 1, 1458–1461. [Google Scholar] [CrossRef]
- Ruano-Rosa, D.; Del Moral-Navarrete, L.; López-Herrera, C.J. Selection of Trichoderma spp. isolates antagonistic to Rosellinia necatrix. Span. J. Agric. Res. 2010, 8, 1084–1097. [Google Scholar] [CrossRef]
- Ahsan, T. In-vitro Biocontrol Activity of a Novel Soil Strain Streptomyces albidoflavus Against Fusarium oxysporum as Causal Agent of Fusarium wilt in Banana Plants. Biosci. Biotechnol. Res. Commun. 2021, 14, 509–517. [Google Scholar] [CrossRef]
- Yang, K.; Zheng, K.B.; Huang, X.H.; Yuan, J.; Chen, J. Identification and antifungal activity of marine Bacillus velezensis strain TCS001. Chin. J. Pestic. Sci. 2018, 20, 333–339. (In Chinese) [Google Scholar] [CrossRef]
- Azabou, M.C.; Gharbi, Y.; Medhioub, I.; Ennouri, K.; Barham, H.; Tounsi, S.; Triki, M.A. The endophytic strain Bacillus velezensis OEE1: An efficient biocontrol agent against Verticillium wilt of olive and a potential plant growth promoting bacteria. Biol. Control 2020, 142, 104168. [Google Scholar] [CrossRef]
- Hu, X.; Cheng, B.; Du, D.; Huang, Z.; Pu, Z.; Chen, G.; Peng, A.; Lu, L. Isolation and identification of a marine actinomycete strain and its control efficacy against citrus green and blue moulds. Biotechnol. Biotechnol. Equip. 2019, 33, 719–729. [Google Scholar] [CrossRef]
- Chaitanya, K.; Masih, H.; Abhiram, P. Isolation of Trichoderma harzianum and Evaluation of Antagonistic Potential against Alternaria alternata. Int. J. Curr. Microbiol. Appl. Sci. 2018, 7, 2910–2918. [Google Scholar] [CrossRef]
- Wu, Q.; Sun, R.; Ni, M.; Yu, J.; Li, Y.; Yu, C.; Dou, K.; Ren, J.; Chen, J. Identification of a novel fungus, Trichoderma asperellum GDFS1009, and comprehensive evaluation of its biocontrol efficacy. PLoS ONE 2017, 12, e0179957. [Google Scholar] [CrossRef]
- Kottb, M.; Gigolashvili, T.; Großkinsky, D.K.; Piechulla, B. Trichoderma volatiles effecting Arabidopsis: From inhibition to protection against phytopathogenic fungi. Front. Microbiol. 2015, 6, 995. [Google Scholar] [CrossRef] [Green Version]
- Ren, D.; Wang, X.; Yang, M.; Yang, L.; He, G.; Deng, X.W. A new regulator of seed size control in Arabidopsis identified by a genome-wide association study. New Phytol. 2018, 222, 895–906. [Google Scholar] [CrossRef]
- Hernández, I.G.; Gomez, F.J.V.; Cerutti, S.; Arana, M.V.; Silva, M.F. Melatonin in Arabidopsis thaliana acts as plant growth regulator at low concentrations and preserves seed viability at high concentrations. Plant Physiol. Biochem. 2015, 94, 191–196. [Google Scholar] [CrossRef]
- Contreras-Cornejo, H.A.; Macías-Rodríguez, L.; Herrera-Estrella, A.; López-Bucio, J. The 4-phosphopantetheinyl transferase of Trichoderma virens plays a role in plant protection against Botrytis cinerea through volatile organic compound emission. Plant Soil 2014, 379, 261–274. [Google Scholar] [CrossRef]
- Javvaji, P.K.; Dhali, A.; Francis, J.R.; Kolte, A.P.; Mech, A.; Roy, S.C.; Mishra, A.; Bhatta, R. An Efficient Nitroblue Tetrazolium Staining and Bright-Field Microscopy Based Method for Detecting and Quantifying Intracellular Reactive Oxygen Species in Oocytes, Cumulus Cells and Embryos. Front. Cell Dev. Biol. 2020, 8, 764. [Google Scholar] [CrossRef] [PubMed]
- Xu, B.; Zang, S.-C.; Li, S.-Z.; Guo, J.-R.; Wang, J.-F.; Wang, D.; Zhang, L.-P.; Yang, H.-M.; Lian, S. HMGB1-mediated differential response on hippocampal neurotransmitter disorder and neuroinflammation in adolescent male and female mice following cold exposure. Brain Behav. Immun. 2019, 76, 223–235. [Google Scholar] [CrossRef] [PubMed]
- Wang, M.; Duan, Y.N.; Sun, S.Y.; Xiang, L.; Wang, G.S.; Chen, X.S.; Sen, X.; Yin, C.M.; Mao, Z.Q. Effects of different nitrogen forms on the growth of replanted apple rootstock (Malus hupehensis Rehd.) seedlings and Fusarium oxysporum population in soil. J. Plant Nutr. Fertil. 2017, 23, 1014–1021. (In Chinese) [Google Scholar] [CrossRef]
- Sun, D.; Sun, X.; Xu, Y.; Wu, T.; Tao, L. Superoxide dismutase activity and risk of cognitive decline in older adults: Findings from the Chinese Longitudinal Healthy Longevity Survey. Exp. Gerontol. 2019, 118, 72–77. [Google Scholar] [CrossRef]
- Omran, R.G. Peroxide Levels and the Activities of Catalase, Peroxidase, and Indoleacetic Acid Oxidase during and after Chilling Cucumber Seedlings. Plant Physiol. 1980, 65, 407–408. [Google Scholar] [CrossRef] [PubMed] [Green Version]
- Singh, B.; Sharma, S. Antioxidant enzymes in cabbage: Variability and inheritance of superoxide dismutase, peroxidase and catalase. Sci. Hortic. 2010, 124, 9–13. [Google Scholar] [CrossRef]
- Phoka, N.; Suwannarach, N.; Lumyong, S.; Ito, S.-I.; Matsui, K.; Arikit, S.; Sunpapao, A. Role of Volatiles from the Endophytic Fungus Trichoderma asperelloides PSU-P1 in Biocontrol Potential and in Promoting the Plant Growth of Arabidopsis thaliana. J. Fungi 2020, 6, 341. [Google Scholar] [CrossRef] [PubMed]
- Kumar, N.; Khurana, S.P. Trichoderma-plant-pathogen interactions for benefit of agriculture and environment. Biocontrol Agents Second. Metab. 2021, 41–63. [Google Scholar] [CrossRef]
- Divya, L.; Sadasivan, C. Trichoderma viride Laccase Plays a Crucial Role in Defense Mechanism against Antagonistic Organisms. Front. Microbiol. 2016, 7, 741. [Google Scholar] [CrossRef]
- Bhale, U.; Rajkonda, J. Enzymatic activity of Trichoderma species. J. Nov. Nat. Sci. Res. 2012, 1, 1–8. [Google Scholar]
- Contreras-Cornejo, H.A.; Macías-Rodríguez, L.; Del-Val, E.; Larsen, J. Ecological functions of Trichoderma spp. and their secondary metabolites in the rhizosphere: Interactions with plants. FEMS Microbiol. Ecol. 2016, 92, fiw036. [Google Scholar] [CrossRef] [PubMed] [Green Version]
- Benítez, T.; Rincón, A.M.; Limón, M.C.; Codón, A.C. Biocontrol mechanisms of Trichoderma strains. Int. Microbiol. 2004, 7, 249–260. [Google Scholar] [CrossRef] [PubMed]
- Vinale, F.; Sivasithamparam, K. Beneficial effects of Trichoderma secondary metabolites on crops. Phytother. Res. 2020, 34, 2835–2842. [Google Scholar] [CrossRef]
- Romero-Guido, C.; Belo, I.; Ta, T.M.N.; Cao-Hoang, L.; Alchihab, M.; Gomes, N.; Thonart, P.; Teixeira, J.; Destain, J.; Waché, Y. Biochemistry of lactone formation in yeast and fungi and its utilisation for the production of flavour and fragrance compounds. Appl. Microbiol. Biotechnol. 2010, 89, 535–547. [Google Scholar] [CrossRef]
- Manganiello, G.; Sacco, A.; Ercolano, M.R.; Vinale, F.; Lanzuise, S.; Pascale, A.; Napolitano, M.; Lombardi, N.; Lorito, M.; Woo, S.L. Modulation of Tomato Response to Rhizoctonia solani by Trichoderma harzianum and Its Secondary Metabolite Harzianic Acid. Front. Microbiol. 2018, 9, 1966. [Google Scholar] [CrossRef] [PubMed]
- Estrada-Rivera, M.; Rebolledo-Prudencio, O.G.; Pérez-Robles, D.A.; Rocha-Medina, M.D.C.; González-López, M.D.C.; Casas-Flores, S. Trichoderma Histone Deacetylase HDA-2 Modulates Multiple Responses in Arabidopsis. Plant Physiol. 2019, 179, 1343–1361. [Google Scholar] [CrossRef] [PubMed] [Green Version]
- Nieto-Jacobo, M.F.; Steyaert, J.M.; Badillo, F.B.S.; Nguyen, D.V.; Rostás, M.; Braithwaite, M.; De Souza, J.T.; Jimenez-Bremont, J.F.; Ohkura, M.; Stewart, A.; et al. Environmental Growth Conditions of Trichoderma spp. Affects Indole Acetic Acid Derivatives, Volatile Organic Compounds, and Plant Growth Promotion. Front. Plant Sci. 2017, 8, 102. [Google Scholar] [CrossRef] [PubMed] [Green Version]
- Miethke, M. Molecular strategies of microbial iron assimilation: From high-affinity complexes to cofactor assembly systems. Metallomics 2013, 5, 15–28. [Google Scholar] [CrossRef]
- Altomare, C.; Norvell, W.A.; Björkman, T.; Harman, G.E. Solubilization of Phosphates and Micronutrients by the Plant-Growth-Promoting and Biocontrol Fungus Trichoderma harzianum Rifai 1295-22. Appl. Environ. Microbiol. 1999, 65, 2926–2933. [Google Scholar] [CrossRef] [PubMed] [Green Version]
- Sumayo, M.; Ghim, S.Y. Plant growth-promoting rhizobacteria for plant immunity. In Bacteria in Agrobiology: Crop Productivity; Maheshwari, D., Saraf, M., Aeron, A., Eds.; Springer: Berlin/Heidelberg, Germany, 2013; pp. 329–349. [Google Scholar] [CrossRef]
- González-Pérez, E.; Ortega-Amaro, M.A.; Salazar-Badillo, F.B.; Bautista, E.; Douterlungne, D.; Jiménez-Bremont, J.F. The Arabidopsis-Trichoderma interaction reveals that the fungal growth medium is an important factor in plant growth induction. Sci. Rep. 2018, 8, 16427. [Google Scholar] [CrossRef] [Green Version]
- Hung, R.; Lee, S.; Bennett, J.W. Arabidopsis thaliana as a model system for testing the effect of Trichoderma volatile organic compounds. Fungal Ecol. 2013, 6, 19–26. [Google Scholar] [CrossRef]
- Li, X.; Garbeva, P.; Liu, X.; Gunnewiek, P.J.A.K.; Clocchiatti, A.; Hundscheid, M.P.J.; Wang, X.; De Boer, W. Volatile-mediated antagonism of soil bacterial communities against fungi. Environ. Microbiol. 2020, 22, 1025–1035. [Google Scholar] [CrossRef] [Green Version]
- García-Gómez, P.; Almagro, G.; Sánchez-López, Á.M.; Bahaji, A.; Ameztoy, K.; Ricarte-Bermejo, A.; Baslam, M.; Antolín, M.C.; Urdiain, A.; López-Belchi, M.D.; et al. Volatile compounds other than CO2 emitted by different microorganisms promote distinct posttranscriptionally regulated responses in plants. Plant Cell Environ. 2019, 42, 1729–1746. [Google Scholar] [CrossRef] [PubMed] [Green Version]
- Salwan, R.; Rialch, N.; Sharma, V. Bioactive Volatile Metabolites of Trichoderma: An overview. In Secondary Metabolites of Plant Growth Promoting Rhizomicroorganisms; Springer: Singapore, 2019; pp. 87–111. [Google Scholar] [CrossRef]
- Cottier, F.; Mühlschlegel, F.A. Communication in Fungi. Int. J. Microbiol. 2011, 2012, 351832. [Google Scholar] [CrossRef] [PubMed] [Green Version]
- Zin, N.A.; Badaluddin, N.A. Biological functions of Trichoderma spp. for agriculture applications. Ann. Agric. Sci. 2020, 65, 168–178. [Google Scholar] [CrossRef]

| Retention Time | Area (%) | Possible Compounds | Molecular Formula | CAS Number |
|---|---|---|---|---|
| 23.341 | 36.45 | 2H-Pyran-2-one, 6-pentyl- | C10H14O2 | 27593-23-3 |
| 11.081 | 7.09 | Cyclotrisiloxane, hexamethyl- | C6H18O3Si3 | 541-05-9 |
| 14.831 | 6.43 | Furan, 2-pentyl- | C9H14O | 003777-69-3 |
| 14.549 | 3.34 | Cyclotetrasiloxane, octamethyl- | C8H24O4Si4 | 556-67-2 |
| 8.73 | 2.68 | Silanediol, dimethyl- | C2H8O2Si | 1066-42-8 |
| 8.766 | 2.6 | Silanediol, dimethyl- | C2H8O2Si | 1066-42-8 |
| 23.978 | 2.51 | Butylated Hydroxytoluene | C15H24O | 128-37-0 |
| 20.65 | 2.42 | Cyclohexasiloxane, dodecamethyl- | C12H36O6Si6 | 540-97-6 |
| 15.535 | 2.38 | 1-Hexanol, 2-ethyl-, (S)- | C8H18O | 128821-84-1 |
| 17.613 | 2.31 | Cyclopentasiloxane, decamethyl- | C10H30O5Si5 | 541-02-6 |
| 9.659 | 1.65 | 1-Pentanol | C5H12O | 71-41-0 |
| 23.267 | 1.16 | Cycloheptasiloxane, tetradecamethyl- | C14H42O7Si7 | 107-50-6 |
| 16.778 | 1.15 | 2,5-Dihydroxybenzaldehyde | C7H6O3 | 1194-98-5 |
| 12.611 | 1.06 | Oxime-, methoxy-phenyl-_ | C8H9NO2 | - |
| 25.474 | 0.95 | Cyclooctasiloxane, hexadecamethyl- | C16H48O8Si8 | 556-68-3 |
| 13.704 | 0.94 | 4′,6′-Dimethoxy-2′,3′-dimethylacetophenone | C12H16O3 | - |
| 24.469 | 0.52 | Octanal, 7-methoxy-3,7-dimethyl-, (S)- | C11H22O2 | 134678-53-8 |
| 24.748 | 0.51 | Cyclobarbital | C12H16N2O3 | 52-31-3 |
Publisher’s Note: MDPI stays neutral with regard to jurisdictional claims in published maps and institutional affiliations. |
© 2021 by the authors. Licensee MDPI, Basel, Switzerland. This article is an open access article distributed under the terms and conditions of the Creative Commons Attribution (CC BY) license (https://creativecommons.org/licenses/by/4.0/).
Share and Cite
Wang, H.; Zhang, R.; Duan, Y.; Jiang, W.; Chen, X.; Shen, X.; Yin, C.; Mao, Z. The Endophytic Strain Trichoderma asperellum 6S-2: An Efficient Biocontrol Agent against Apple Replant Disease in China and a Potential Plant-Growth-Promoting Fungus. J. Fungi 2021, 7, 1050. https://doi.org/10.3390/jof7121050
Wang H, Zhang R, Duan Y, Jiang W, Chen X, Shen X, Yin C, Mao Z. The Endophytic Strain Trichoderma asperellum 6S-2: An Efficient Biocontrol Agent against Apple Replant Disease in China and a Potential Plant-Growth-Promoting Fungus. Journal of Fungi. 2021; 7(12):1050. https://doi.org/10.3390/jof7121050
Chicago/Turabian StyleWang, Haiyan, Rong Zhang, Yanan Duan, Weitao Jiang, Xuesen Chen, Xiang Shen, Chengmiao Yin, and Zhiquan Mao. 2021. "The Endophytic Strain Trichoderma asperellum 6S-2: An Efficient Biocontrol Agent against Apple Replant Disease in China and a Potential Plant-Growth-Promoting Fungus" Journal of Fungi 7, no. 12: 1050. https://doi.org/10.3390/jof7121050
APA StyleWang, H., Zhang, R., Duan, Y., Jiang, W., Chen, X., Shen, X., Yin, C., & Mao, Z. (2021). The Endophytic Strain Trichoderma asperellum 6S-2: An Efficient Biocontrol Agent against Apple Replant Disease in China and a Potential Plant-Growth-Promoting Fungus. Journal of Fungi, 7(12), 1050. https://doi.org/10.3390/jof7121050






